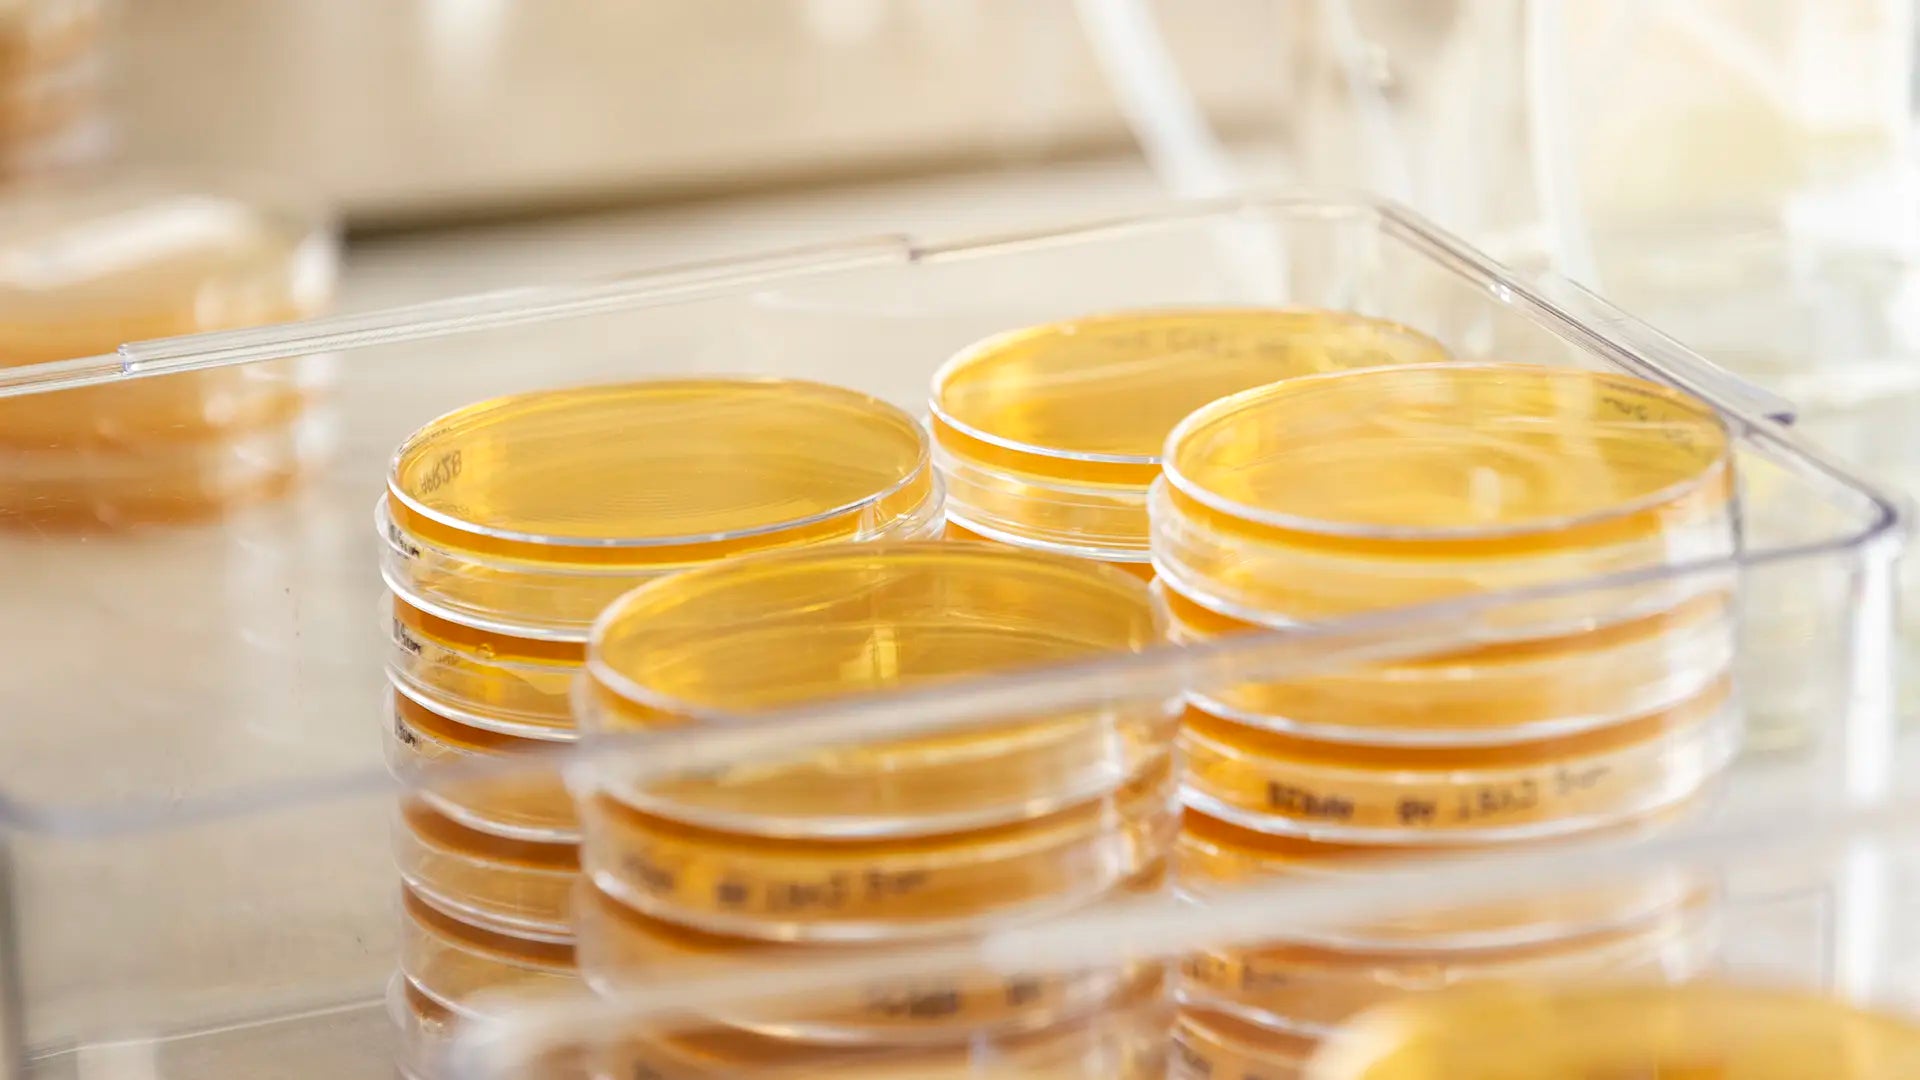
Banner Image

CFU in probiotics explained

CFU, or colony-forming units, is the standard way to measure the number of live bacteria in a probiotic. At BioGaia, we focus on scientifically researched strains, carefully produced to maintain quality and consistency rather than just high numbers.
CFU in Probiotics: Explained by a BioGaia Scientist

Why CFU Matters
What sets BioGaia apart is that the CFU amount is guaranteed until the expiry date, not just at manufacture. This ensures the product maintains its intended potency over time. It’s an important measure of quality, helping consumers know they’re getting a reliable, carefully produced probiotic every time.
All BioGaia® products are checked with SelectBiotics™, a new trusted standard for premium probiotics. Backed by over 30 years of research, our products are carefully tested and designed with advanced CFU protection, including LongevityGuard™, to maintain quality right through to the expiry date.
How Many CFU Should I Take?
At BioGaia, we focus on quality over quantity. The right amount of CFU (colony-forming units) isn’t about taking the highest number possible — it’s about taking a scientifically researched strain in a carefully measured dose. Our products are designed to deliver consistent CFU until the expiry date, ensuring that what’s on the label is what you actually get.
Because different probiotic strains are studied at different amounts, there isn’t a one-size-fits-all number of CFU to take. What matters most is choosing a reliable, well-researched product — like BioGaia — where both the strain and the dose have been carefully tested.



